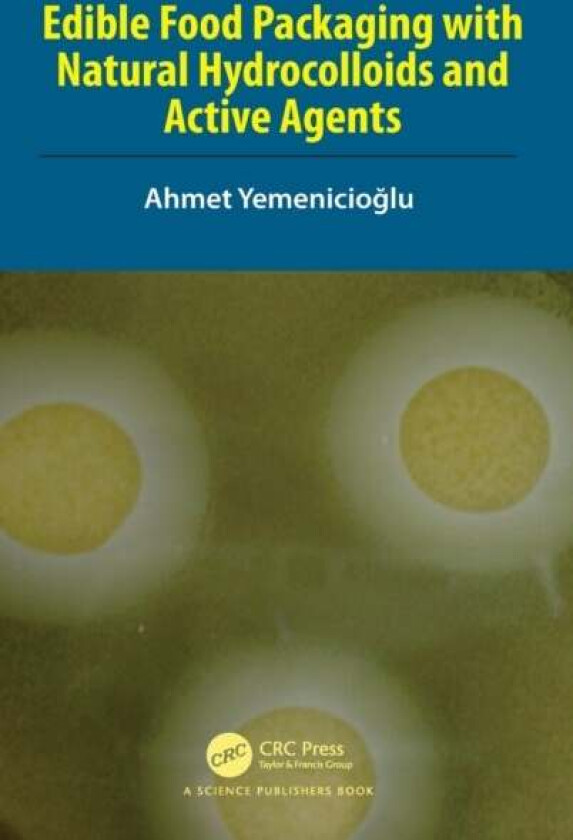
Edible Food Packaging with Natural Hydrocolloids and Active Agents av Ahmet (Izmir Institute of Technology) Yemenicioglu

Edible Food Packaging with Natural Hydrocolloids and Active Agents av Ahmet (Izmir Institute of Technology) Yemenicioglu
Beste pris fra kr 1 879 og finnes i 1 butikk.
Populære alternativer
Populære merker innen Bøker
Prishistorikk
Prisvarsel
Meld deg opp til prisvarsel og få beskjed med en gang prisen synker.
kr
Egenskaper og detaljer
Generelt
Kategori
Fagbøker, Matematikk og naturvitenskap, Kjemi
Strekkoder
GTIN
9780367350192










